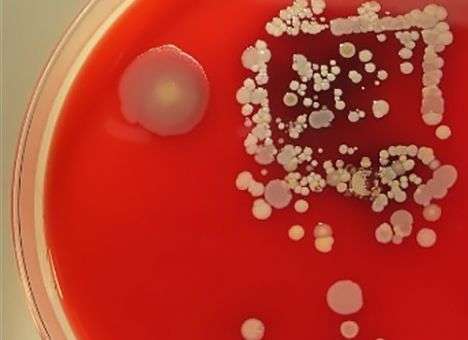
Придуман способ заставить врачей более ответственно относиться к гигиене

Рубрики
МЕНЮ
Придуман способ заставить врачей более ответственно относиться к гигиене
Сотрудники медучреждений моют руки в два раза реже, чем это необходимо

Виталий Войчук
Многие медицинские работники моют руки не так часто и не так тщательно, как это необходимо, пишет "medportal.ru". Согласно данным, предоставленным Центром по контролю заболеваний США (Centers for Disease Control and Prevention), сотрудники медучреждений моют руки в два раза реже, чем это необходимо. Соблюдение же правил гигиены позволяет предотвратить распространение инфекций, считают эксперты.
Специалисты одной из больниц Детройта придумали способ заставить врачей более ответственно относиться к гигиене.
Они решили показать фотографии микроорганизмов, которые присутствуют на различных больничных поверхностях. Были взяты пробы с дверных ручек, компьютерной мышки от больничного компьютера, ультразвукового аппарата, мобильных телефонов и рук самих сотрудников больницы. Микроорганизмы культивировались на питательной среде в чашках Петри, после чего чашки были сфотографированы и в течение двух месяцев демонстрировались медработникам четырех отделений больницы, уровень гигиены в которых был наименьшим.
Исследователи во главе с Эшли Грегори (Ashley Gregory) обнаружили, что после того, как фотографии больничных микроорганизмов были показаны сотрудникам больницы, медработники стали мыть руки на 11% чаще, а в одном отделении этот показатель увеличился на 50%.
Фото: CNN
Читайте Comments.ua в Google News
Новости партнеров



